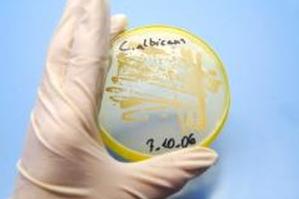

Многим женщинам приходилось бороться с кандидозными дрожжевыми инфекциями, также известными как молочница, но немногие знают, что у них также могут развиться кандидозные родинки на коже . Они будут непривлекательными, но, к счастью, не так опасны, как серьезные проблемы с кандидозом под кожей, и в большинстве случаев их можно лечить без посещения врача.
Что такое кандидозные родинки на коже?
Грибок Candida albicans гораздо более распространен, чем известно большинству людей, и присутствует почти у всех, но лишь немногие люди будут страдать от него. Для большинства больных кандидозный дисбаланс приводит к дрожжевой инфекции, обнаруживаемой либо во влагалище, либо во рту, либо в обоих случаях. Многие предпочитают лечить эту версию кандиды комплексными добавками и некоторыми диетическими изменениями, такими как снижение потребления сахара. Как только кандидоз будет определен как проблема, его можно контролировать с помощью некоторых корректировок образа жизни.
Однако кандидозные родинки на коже имеют более вирулентное происхождение при кандидозе глубоких органов, и это может проявляться на любой части тела. Это чаще наблюдается у людей с подавленной или иным образом нарушенной иммунной системой, скорее всего, из-за болезни, или у тех, кто проходит курс антибиотиков. Если они появляются во рту, они будут белыми и кремообразными. Родинки внутри влагалища будут красными и воспаленными, появится ощущение зуда и жжения. Помимо родинок, кандидоз в любом месте на коже принимает форму сыпи красного цвета, приподнятой и иногда чешуйчатой.
Кандидозу подвержены не только женщины. У младенцев может развиться кандидозная сыпь, и известно, что мужчины также страдают от кандидоза на гениталиях.
Когда обращаться за лечением
В то время как кандидозные родинки на коже в лучшем случае непривлекательны, кандидоз, который проявляется только на коже, не опасен и обычно поддается лечению безрецептурными препаратами. Однако, если кандида присутствует на внутренних органах, она может вызвать повреждение, которое начнется с лихорадки, озноба и анемии и распространится дальше, становясь гораздо более опасным. Если вы подозреваете, что страдаете этой формой кандидоза, немедленно обратитесь к врачу.
Лечение родинок на коже Candida
Профилактика в первую очередь заключается в лечении родинок кандидоза. Если вы знаете, что склонны к ним, вы хотите, чтобы ваша кожа была чистой, сухой и как можно более свободной от ссадин, тем самым устраняя легкую среду для размножения грибка.
Когда на коже присутствуют родинки кандиды, лучший способ их лечения — противогрибковые препараты, такие как Фемизол-7 и Монистат-дерм. Для родинок на влагалище и вокруг него выберите противогрибковые средства, такие как Monistat Vagina, Vagistat Vagina или Gyne-Lotrimin. Вы можете предпочесть принимать пероральные лекарства от вагинального кандидоза, а не возиться с кремами. Чистота и поддержание сухости имеет первостепенное значение. Предпочтительно носить полностью натуральное хлопковое нижнее белье для максимальной воздухопроницаемости — опять же, это дает бактериям меньше возможностей для роста.
Профилактика кандидоза с помощью диеты
Натуропаты, диетологи и другие специалисты в области холистической медицины выступают за диету.с низким содержанием дрожжей и белого обработанного сахара, чтобы снизить уровень кандиды. При составлении строгой кандидозной диеты лучше всего проконсультироваться с диетологом, но вы можете начать с ограничения углеводов до 60 граммов в день. Это, однако, зависит от ряда факторов, поэтому вам следует обратиться к профессионалу. Акцент делается на большем количестве мяса и некрахмалистых овощей. Особенно следует избегать продуктов, способствующих развитию дрожжей, к которым помимо сахара относятся дрожжевой хлеб, сыр, томатная паста и грибы. Многие люди обнаруживают, что в конечном итоге они могут снова включить эти продукты в свой рацион. Ключом к управлению кандидозом является внимание и понимание своего тела. Это может быть неудобно, но не должно быть изнурительным.